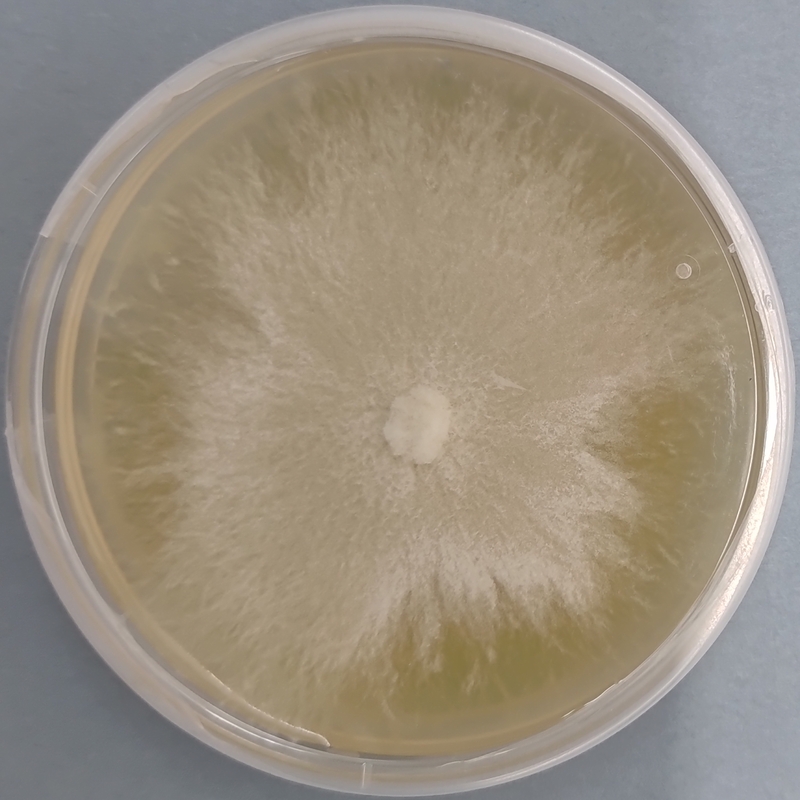

Pleurotus djamor (Sakura / Pink Oyster) โ Pure Culture Plate
The Sakura Oyster Mushroom (Pleurotus djamor), also known as the Pink Oyster, is one of the most visually striking and fast-growing oyster species. It produces vibrant pink clusters with a delicate floral aroma and a firm, meaty texture. When cooked, it develops a mild, nutty flavor โ making it a favorite among gourmet chefs and exotic mushroom growers.
Our pure culture plates are aseptically prepared to ensure contamination-free, genetically pure mycelium. This tropical species performs exceptionally well in warm environments, exhibiting rapid colonization and short cropping cycles. Itโs perfect for both beginners and professionals looking for quick returns and aesthetic appeal.
Ideal for:
Commercial spawn and fruiting block preparation
Warm-region mushroom cultivation
Educational, hobby, and demonstration setups
Key Features:
Striking pink color and fast fruiting cycle (12โ18 days)
Thrives in warm climates (24โ32ยฐC)
Rapid mycelial growth with strong substrate colonization
Best grown on straw, sawdust, or mixed agricultural residues
Excellent culinary appeal and local market value
๐ Proudly prepared and stored at Agripie Agrosystem LLP, India ๐ฎ๐ณ

|
| 
